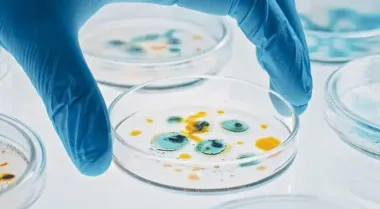

Ученые обнаружили неизвестный живой организм на китайской космической станции "Тяньгун"
focus.ua
Mon, 19 May 2025 10:43:01 +0300
Китайские ученые обнаружили новый штамм бактерий на борту космической станции “Тяньгун”, который является новым вариантом известной земной бактерии.
Последние новости
